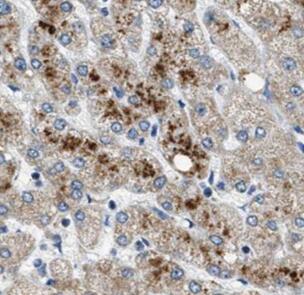
Histone H3.3 antibody

Histone H3.3 antibody
Histone H3.3 antibody
询价
100μg
起订
湖北 更新日期:2026-04-05
产品详情:
- 英文名称:
- Histone H3.3 antibody
- 产品类别:
- 蛋白抗体
- 抗体类型:
- 蛋白抗体
- 货号:
- PAab03888
公司简介
维克赛思科技有限公司是一家以销售、服务于一体的生物服务企业,具有先进的信息平台、专业的技术服务人员、成熟的营销网络。 公司主要产品有 质粒、重组蛋白、抗体和试剂盒。公司力争用高质量的产品来促成您获得出色的实验结果。公司将凭借雄厚的技术服务力量、专业的质量管理体系和良好的客户服务意识竭诚为广大科研工作者服务!
| 成立日期 | (7年) |
| 注册资本 | 20万 |
| 员工人数 | 1-10人 |
| 年营业额 | ¥ 300万-500万 |
| 经营模式 | 贸易,试剂 |
| 主营行业 | 生物化工,化学试剂 |
Histone H3.3 antibody相关厂家报价 更多
-

- Histone H3.3 Antibody
- 上海超研生物科技有限公司
- 2026-04-05
- 询价
-

- HistoneH3.3抗体;HistoneH3.3 Antibody—艾普蒂
- 上海切尔齐生物科技有限公司
- 2025-05-29
- 询价
-

- Histone H3片段多肽/917103-17-4/Histone H3 (116-136),C116-136
- 南京肽研生物科技有限公司 VIP
- 2026-04-05
- ¥1050
-

- 刻度量筒,高型,SILBERBRAND, B级,25:0..5 ml, Boro 3.3|25:0..5 ml, Boro 3.3|Brand/普兰德
- BRAND(Shanghai)TradingCo.,Ltd.
- 2026-04-05
- ¥167.04
-

- Histone H3.3 Rabbit Monoclonal Antibody
- 碧云天生物技术有限公司
- 2026-04-05
- 询价